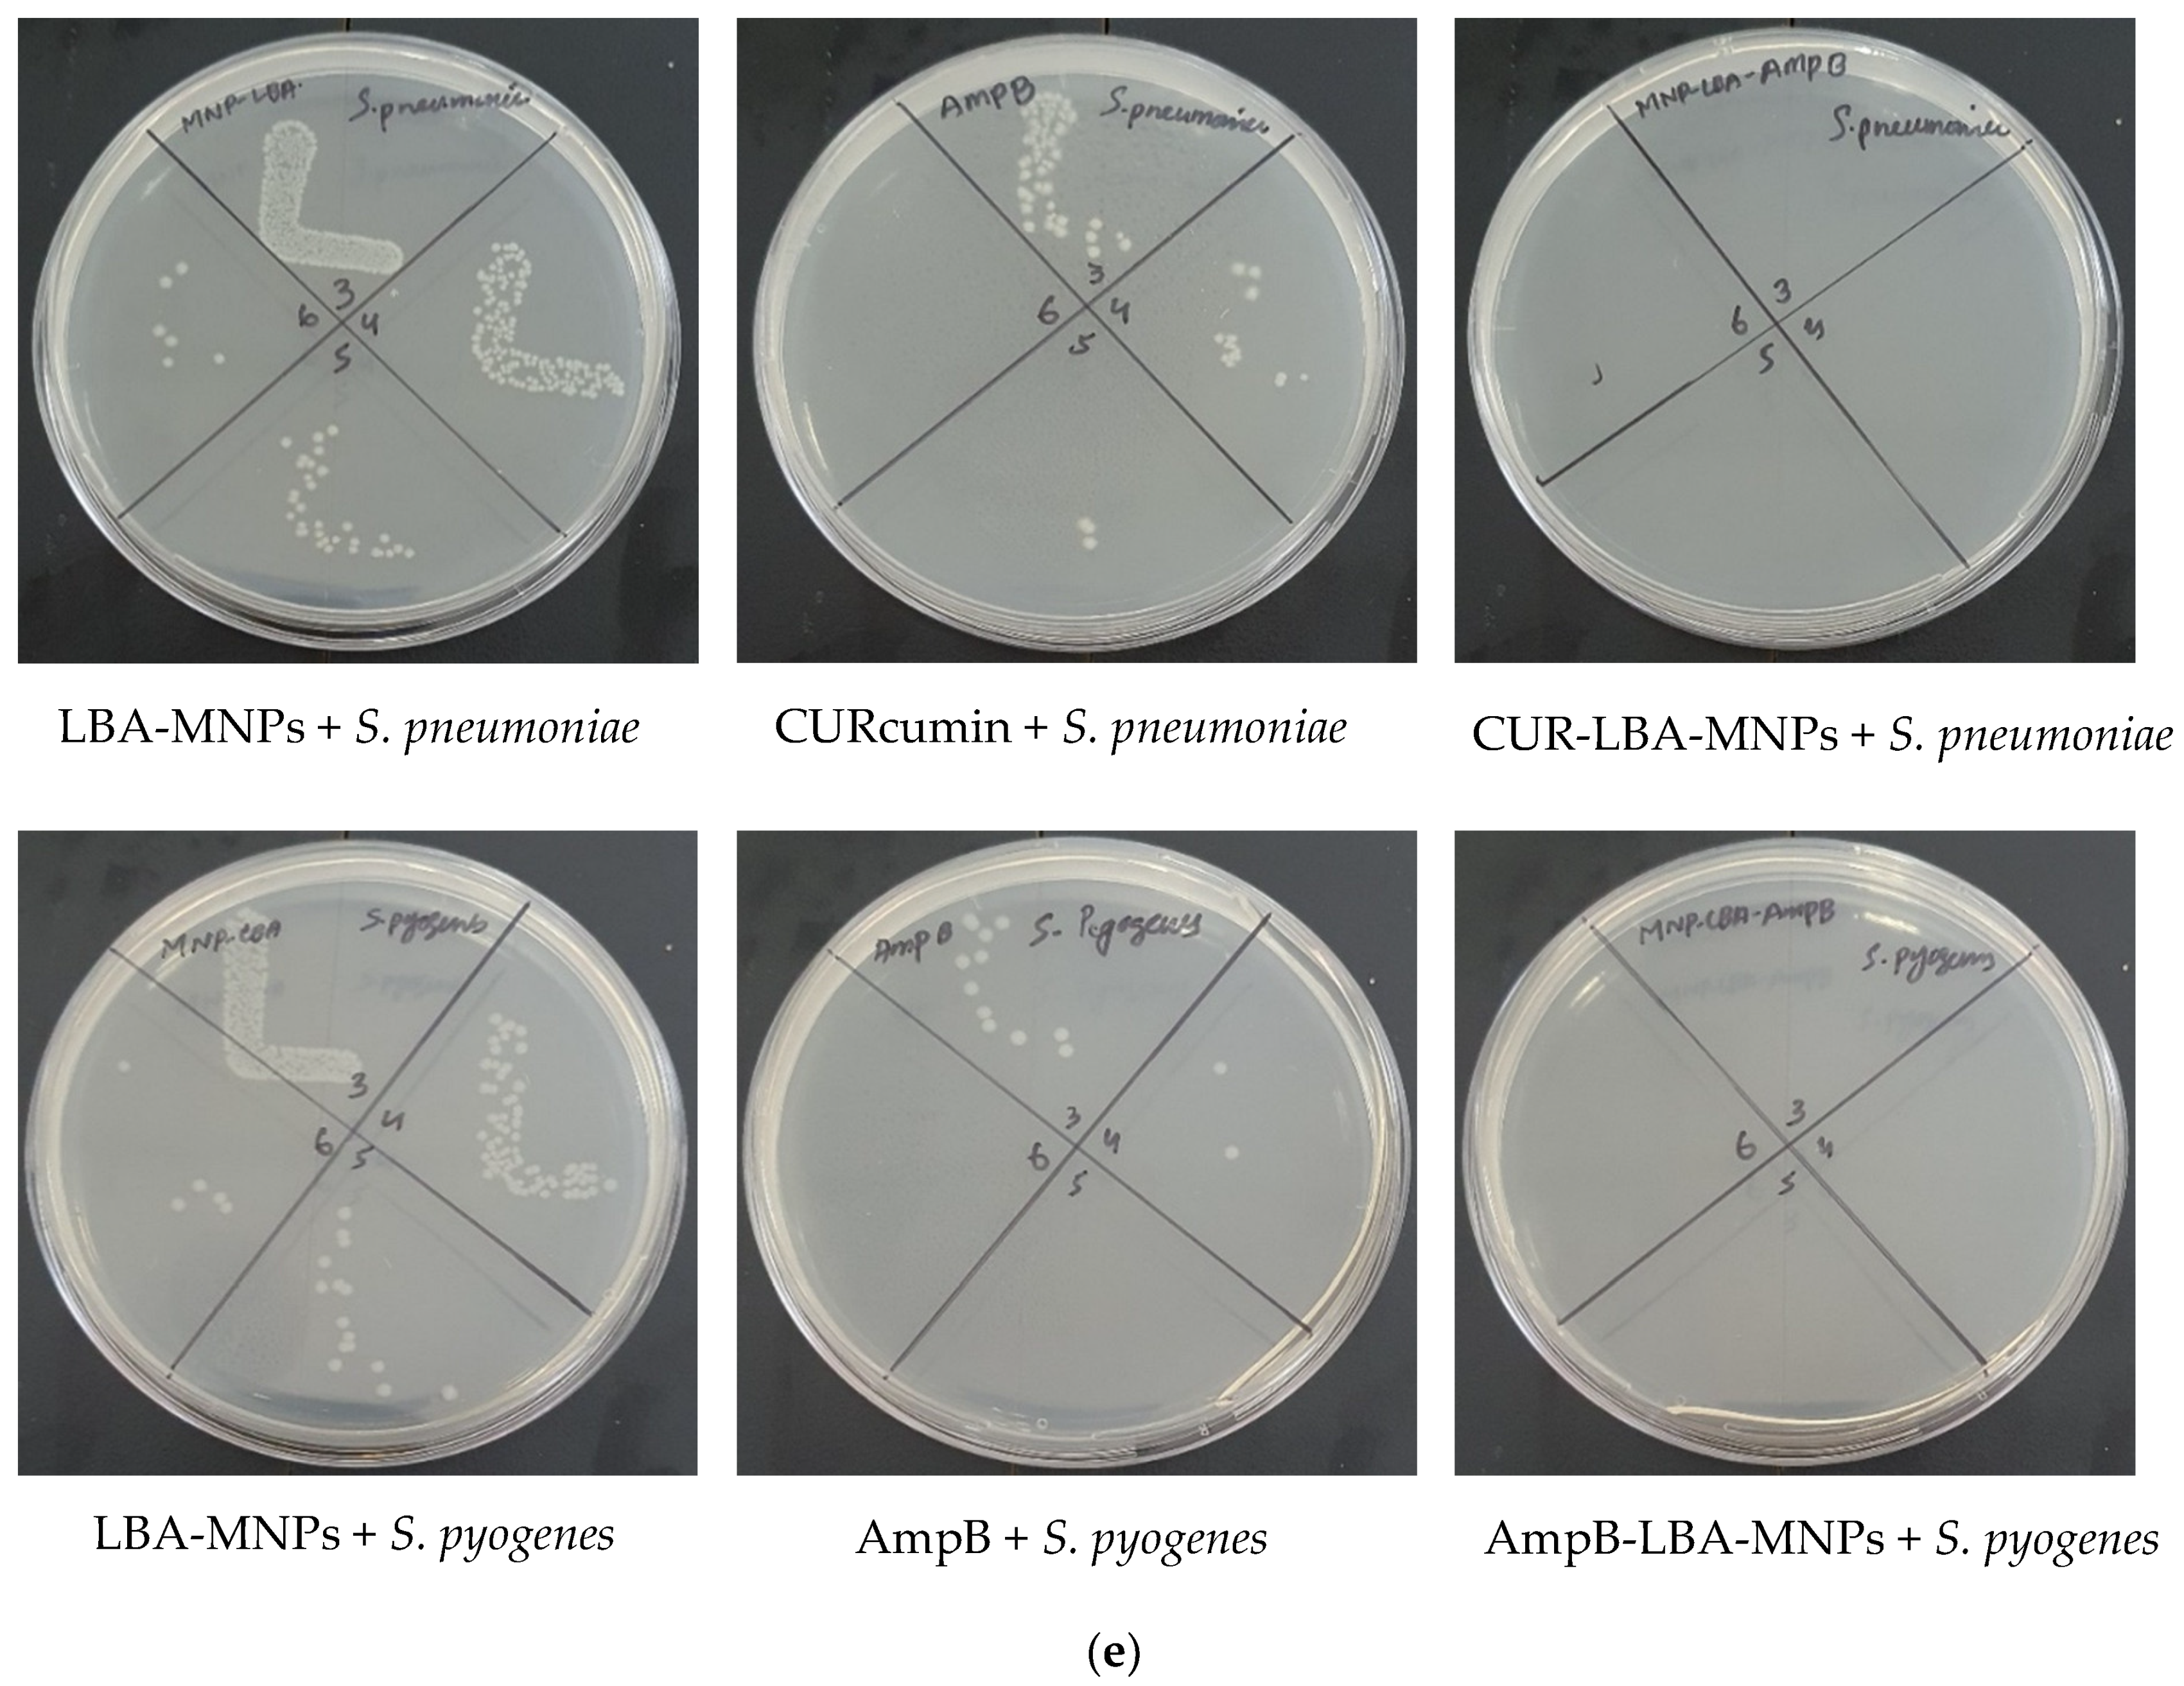

Hesperidin-, Curcumin-, and Amphotericin B- Based Nano-Formulations as Potential Antibacterials
Abstract
1. Introduction
2. Materials and Methods
2.1. Materials
2.2. Preparation of CA-MNPs and HES-CA-MNPs Formulations
2.3. Preparation of LBA-MNPs, CUR-LBA-MNPs, and AmpB-LBA-MNPs
2.4. Hydrodynamic Diameter, Polydispersity Index (PDI), and Morphology
2.5. Drug-Loading Efficiency Determination
2.6. Bacteria Used in This Study
2.7. In Vitro Antibacterial Assays
2.8. Minimum Inhibitory Concentration
2.9. In Vitro Cell Cytotoxicity Assays
2.10. In Vitro Release Study
2.11. Statistical Analysis
3. Results
3.1. Preparation of CA-MNPs and HES-CA-MNPs Formulations
3.2. Preparation of LBA-MNPs, CUR-LBA-MNPs, and AmpB-LBA-MNPs
3.3. Hydrodynamic Diameter, Polydispersity Index (PDI), and Morphology
3.4. Drug-Loading Efficiency
3.5. Drugs and Drug–Nanoparticle Formulations Presented Imperative Bactericidal Activities against MDR Pathogenic Bacteria
3.6. Drugs and Drug–NP Conjugates Confirmed Marginal Cytotoxicity
3.7. In Vitro Release Study
4. Discussion
Author Contributions
Funding
Institutional Review Board Statement
Informed Consent Statement
Data Availability Statement
Acknowledgments
Conflicts of Interest
References
- Fair, R.J.; Tor, Y. Antibiotics and Bacterial Resistance in the 21st Century. Perspect. Med. Chem. 2014, 6, 25–64. [Google Scholar] [CrossRef] [PubMed]
- Ventola, C.L. The Antibiotic Resistance Crisis: Part 1: Causes and Threats. Pharm. Ther. 2015, 40, 277–283. [Google Scholar]
- Spellberg, B.; Bartlett, J.G.; Gilbert, D.N. The Future of Antibiotics and Resistance. N. Engl. J. Med. 2013, 368, 299–302. [Google Scholar] [CrossRef] [PubMed]
- Ogawara, H. Comparison of Antibiotic Resistance Mechanisms in Antibiotic-Producing and Pathogenic Bacteria. Molecules 2019, 24, 3430. [Google Scholar] [CrossRef] [PubMed]
- Rice, L.B. Federal Funding for the Study of Antimicrobial Resistance in Nosocomial Pathogens: No ESKAPE. J. Infect. Dis. 2008, 197, 1079–1081. [Google Scholar] [CrossRef]
- Lee, N.; Ko, W.; Hsueh, P. Nanoparticles in the Treatment of Infections Caused by Multidrug-Resistant Organisms. Front. Pharmacol. 2019, 10, 1153. [Google Scholar] [CrossRef]
- Blecher, K.; Nasir, A.; Friedman, A. The Growing Role of Nanotechnology in Combating Infectious Disease. Virulence 2011, 2, 395–401. [Google Scholar] [CrossRef]
- Hindi, K.M.; Ditto, A.J.; Panzner, M.J.; Medvetz, D.A.; Han, D.S.; Hovis, C.E.; Hilliard, J.K.; Taylor, J.B.; Yun, Y.H.; Cannon, C.L.; et al. The Antimicrobial Efficacy of Sustained Release Silver–Carbene Complex-Loaded l-Tyrosine Polyphosphate Nanoparticles: Characterization, in Vitro and in Vivo Studies. Biomaterials 2009, 30, 3771–3779. [Google Scholar] [CrossRef]
- Huh, A.J.; Kwon, Y.J. “Nanoantibiotics”: A New Paradigm for Treating Infectious Diseases Using Nanomaterials in the Antibiotics Resistant Era. J. Control Release 2011, 156, 128–145. [Google Scholar] [CrossRef]
- Knetsch, M.L.W.; Koole, L.H. New Strategies in the Development of Antimicrobial Coatings: The Example of Increasing Usage of Silver and Silver Nanoparticles. Polymers 2011, 3, 340–366. [Google Scholar] [CrossRef]
- Schairer, D.O.; Chouake, J.S.; Nosanchuk, J.D.; Friedman, A.J. The Potential of Nitric Oxide Releasing Therapies as Antimicrobial Agents. Virulence 2012, 3, 271–279. [Google Scholar] [CrossRef] [PubMed]
- Zhang, L.; Pornpattananangkul, D.; Hu, C.-M.; Huang, C.-M. Development of Nanoparticles for Antimicrobial Drug Delivery. Curr. Med. Chem. 2010, 17, 585–594. [Google Scholar] [CrossRef] [PubMed]
- Hajipour, M.J.; Fromm, K.M.; Ashkarran, A.A.; Aberasturi, J.D.D.; de Larramendi, I.R.; Rojo, T.; Serpooshan, V.; Parak, W.J.; Mahmoudi, M. Antibacterial Properties of Nanoparticles. Trends Biotechnol. 2012, 30, 499–511. [Google Scholar] [CrossRef] [PubMed]
- Huang, C.M.; Chen, C.H.; Pornpattananangkul, D.; Zhang, L.; Chan, M.; Hsieh, M.F.; Zhang, L. Eradication of Drug Resistant Staphylococcus Aureus by Liposomal Oleic Acids. Biomaterials 2011, 32, 214–221. [Google Scholar] [CrossRef] [PubMed]
- Akbar, N.; Kawish, M.; Jabri, T.; Khan, N.A.; Shah, M.R.; Siddiqui, R. Enhancing efficacy of existing antibacterials against selected multiple drug resistant bacteria using cinnamic acid-coated magnetic iron oxide and mesoporous silica nanoparticles. Pathog. Glob. Health 2020, 1–17. [Google Scholar] [CrossRef]
- Chen, Y.L.; Huang, S.T.; Sun, F.M.; Chiang, Y.L.; Chiang, C.J.; Tsai, C.M.; Weng, C.J. Transformation of cinnamic acid from trans-to cis-form raises a notable bactericidal and synergistic activity against multiple-drug resistant Mycobacterium tuberculosis. Eur. J. Pharm. Sci. 2011, 43, 188–194. [Google Scholar] [CrossRef]
- Wu, H.; Yin, J.J.; Wamer, W.G.; Zeng, M.; Lo, Y.M. Reactive oxygen species-related activities of nano-iron metal and nano-iron oxides. J. Food Drug Anal. 2014, 22, 86–94. [Google Scholar] [CrossRef]
- Leid, J.G.; Ditto, A.J.; Knapp, A.; Shah, P.N.; Wright, B.D.; Blust, R.; Christensen, L.; Clemons, C.B.; Wilber, J.P.; Young, G.W.; et al. In Vitro Antimicrobial Studies of Silver Carbene Complexes: Activity of Free and Nanoparticle Carbene Formulations against Clinical Isolates of Pathogenic Bacteria. J. Antimicrob. Chemother. 2012, 67, 138–148. [Google Scholar] [CrossRef]
- Wang, L.; Hu, C.; Shao, L. The Antimicrobial Activity of Nanoparticles: Present Situation and Prospects for the Future. Int. J. Nanomed. 2017, 12, 1227–1249. [Google Scholar] [CrossRef]
- Yeh, Y.C.; Huang, T.H.; Yang, S.C.; Chen, C.C.; Fang, J.Y. Nano-Based Drug Delivery or Targeting to Eradicate Bacteria for Infection Mitigation: A Review of Recent Advances. Front. Chem. 2020, 8, 286. [Google Scholar] [CrossRef]
- Tong, N.; Zhang, Z.; Zhang, W.; Qiu, Y.; Gong, Y.; Yin, L.; Qiu, Q.; Wu, X. Diosmin Alleviates Retinal Edema by Protecting the Blood-Retinal Barrier and Reducing Retinal Vascular Permeability during Ischemia/Reperfusion Injury. PLoS ONE 2013, 8, e61794. [Google Scholar] [CrossRef] [PubMed]
- Anwar, A.; Masri, A.; Rao, K.; Rajendran, K.; Khan, N.A.; Shah, M.R.; Siddiqui, R. Antimicrobial Activities of Green Synthesized Gums-Stabilized Nanoparticles Loaded with Flavonoids. Sci. Rep. 2019, 9, 3122. [Google Scholar] [CrossRef] [PubMed]
- Lee, C.J.; Wilson, L.; Jordan, M.A.; Nguyen, V.; Tang, J.; Smiyun, G. Hesperidin Suppressed Proliferations of Both Human Breast Cancer and Androgen-Dependent Prostate Cancer Cells: Hesperidin Suppressed Proliferation of Human Breast Cancer Cells. Phytother. Res. 2010, 24, S15–S19. [Google Scholar] [CrossRef] [PubMed]
- Sezer, A.; Kocak, Z.; Usta, U.; Yagci, M. The Effect of a Flavonoid Fractions Diosmin + Hesperidin on Radiation-Induced Acute Proctitis in a Rat Model. J. Can. Res. Ther. 2011, 7, 152–156. [Google Scholar] [CrossRef] [PubMed]
- Ali, S.H.; Sulaiman, G.M.; Al-Halbosiy, M.M.; Jabir, M.S.; Hameed, A.H. Fabrication of hesperi-din nanoparticles loaded by poly lactic co-Glycolic acid for improved therapeutic efficiency and cy-totoxicity. Artif. Cells Nanomed. Biotechnol. 2019, 47, 378–394. [Google Scholar] [CrossRef]
- Köksal Karayıldırım, Ç. Characterization and in Vitro Evolution of Antibacterial Efficacy of Novel Hesperidin Microemulsion. Celal Bayar Univ. J. Sci. 2017, 943–947. [Google Scholar] [CrossRef]
- Adamczak, A.; Ożarowski, M.; Karpiński, T.M. CURcumin, a Natural Antimicrobial Agent with Strain-Specific Activity. Pharmaceuticals 2020, 13, 153. [Google Scholar] [CrossRef]
- Saeed, B.Q.; Hussain, K.; Akbar, N.; Khan, H.; Siddiqui, R.; Shah, R.M.; Khan, N.A. Nanovesicles Containing CURcumin Hold Promise in the Development of New Formulations of Anti-Acanthamoebic Agents. Mol. Biochem. Parasitol. 2022, 247, 111430. [Google Scholar] [CrossRef]
- Shlar, I.; Droby, S.; Choudhary, R.; Rodov, V. The Mode of Antimicrobial Action of CURcumin Depends on the Delivery System: Monolithic Nanoparticles vs. Supramolecular Inclusion Complex. RSC Adv. 2017, 7, 42559–42569. [Google Scholar] [CrossRef]
- Brajtburg, J.; Powderly, W.G.; Kobayashi, G.S.; Medoff, G. Amphotericin B: CURrent Understanding of Mechanisms of Action. Antimicrob. Agents Chemother. 1990, 34, 183–188. [Google Scholar] [CrossRef]
- Hartsel, S.; Bolard, J. Amphotericin B: New Life for an Old Drug. Trends Pharmacol. Sci. 1996, 17, 445–449. [Google Scholar] [CrossRef]
- Gao, S.; Zhang, S.; Zhang, S. Enhanced in Vitro Antimicrobial Activity of Amphotericin B with Berberine against Dual-species Biofilms of Candida Albicans and Staphylococcus Aureus. J. Appl. Microbiol. 2021, 130, 1154–1172. [Google Scholar] [CrossRef] [PubMed]
- Venegas, B.; González-Damián, J.; Celis, H.; Ortega-Blake, I. Amphotericin B channels in the bacterial membrane: Role of sterol and temperature. Biophys. J. 2003, 85, 2323–2332. [Google Scholar] [CrossRef][Green Version]
- Kawish, M.; Jabri, T.; Elhissi, A.; Zahid, H.; Muhammad Iqbal, K.; Rao, K.; Gul, J.; Abdullah, M.; Shah, M.R. Galactosylated Iron Oxide Nanoparticles for Enhancing Oral Bioavailability of Ceftriaxone. Pharm. Dev. Technol. 2021, 26, 291–301. [Google Scholar] [CrossRef]
- Agnaniet, H.; Mounzeo, H.; Menut, C.; Bessiere, J.M.; Criton, M. The Essential Oils of Rinorea Subintegrifolia, O. Ktze And Drypetes Gossweileri, S. Moore occurring in Gabon. Flavour Fragr. J. 2003, 18, 207–210. [Google Scholar] [CrossRef]
- Kamruzzaman Selim, K.M.; Ha, Y.S.; Kim, S.J.; Chang, Y.; Kim, T.J.; Ho Lee, G.; Kang, I.K. Surface Modification of Magnetite Nanoparticles Using Lactobionic Acid and Their Interaction with Hepatocytes. Biomaterials 2007, 28, 710–716. [Google Scholar] [CrossRef]
- Pan, Q.; Lv, Y.; Williams, G.R.; Tao, L.; Yang, H.; Li, H.; Zhu, L. Lactobionic Acid and Carboxymethyl Chitosan Functionalized Graphene Oxide Nanocomposites as Targeted Anticancer Drug Delivery Systems. Carbohydr. Polym. 2016, 151, 812–820. [Google Scholar] [CrossRef]
- Katuwavila, N.P.; Amarasekara, Y.; Jayaweera, V.; Rajaphaksha, C.; Gunasekara, C.; Perera, I.C.; Amaratunga, G.A.J.; Weerasinghe, L. Graphene Oxide–Based Nanocomposite for Sustained Release of Cephalexin. J. Pharm. Sci. 2020, 109, 1130–1135. [Google Scholar] [CrossRef]
- Nosrati, H.; Rashidi, N.; Danafar, H.; Manjili, H.K. Anticancer Activity of Tamoxifen Loaded Tyrosine Decorated Biocompatible Fe3O4 Magnetic Nanoparticles Against Breast Cancer Cell Lines. J. Inorg. Organomet. Polym. Mater. 2018, 28, 1178–1186. [Google Scholar] [CrossRef]
- Date, A.A.; Nagarsenker, M.S.; Patere, S.; Dhawan, V.; Gude, R.P.; Hassan, P.A.; Aswal, V.; Steiniger, F.; Thamm, J.; Fahr, A. Lecithin-Based Novel Cationic Nanocarriers (Leciplex) II: Improving Therapeutic Efficacy of Quercetin on Oral Administration. Mol. Pharm. 2011, 8, 716–726. [Google Scholar] [CrossRef]
- Katara, R.; Sachdeva, S.; Majumdar, D.K. Design, Characterization, and Evaluation of Aceclofenac-Loaded Eudragit RS 100 Nanoparticulate System for Ocular Delivery. Pharm. Dev. Technol. 2019, 24, 368–379. [Google Scholar] [CrossRef] [PubMed]
- Akbar, N.; Siddiqui, R.; Iqbal, M.; Khan, N.A. Antibacterial Activities of Selected Pure Compounds Isolated from Gut Bacteria of Animals Living in Polluted Environments. Antibiotics 2020, 9, 190. [Google Scholar] [CrossRef] [PubMed]
- Akbar, N.; Aslam, Z.; Siddiqui, R.; Shah, M.R.; Khan, N.A. Zinc Oxide Nanoparticles Conjugated with Clinically-Approved Medicines as Potential Antibacterial Molecules. AMB Express 2021, 11, 104. [Google Scholar] [CrossRef] [PubMed]
- Ali, S.M.; Siddiqui, R.; Ong, S.-K.; Shah, M.R.; Anwar, A.; Heard, P.J.; Khan, N.A. Identification and Characterization of Antibacterial Compound(s) of Cockroaches (Periplaneta Americana). Appl. Microbiol. Biotechnol. 2017, 101, 253–286. [Google Scholar] [CrossRef]
- Attia, G.H.; Marrez, D.A.; Mohammed, M.A.; Albarqi, H.A.; Ibrahim, A.M.; Raey, M.A.E. Synergistic Effect of Mandarin Peels and Hesperidin with Sodium Nitrite against Some Food Pathogen Microbes. Molecules 2021, 26, 3186. [Google Scholar] [CrossRef]
- Maghsoudi, A.; Yazdian, F.; Shahmoradi, S.; Ghaderi, L.; Hemati, M.; Amoabediny, G. Curcumin-Loaded Polysaccharide Nanoparticles: Optimization and Anticariogenic Activity against Streptococcus Mutans. Mater. Sci. Eng. C 2017, 75, 1259–1267. [Google Scholar] [CrossRef]
- Akbar, N.; Khan, N.A.; Sagathevan, K.; Iqbal, M.; Tawab, A.; Siddiqui, R. Gut Bacteria of Cuora Amboinensis (Turtle) Produce Broad-Spectrum Antibacterial Molecules. Sci. Rep. 2019, 9, 17012. [Google Scholar] [CrossRef]
- Jeyamogan, S.; Khan, N.A.; Anwar, A.; Shah, M.R.; Siddiqui, R. Cytotoxic Effects of Benzodioxane, Naphthalene Diimide, Porphyrin and Acetamol Derivatives on HeLa Cells. SAGE Open Med. 2018, 6, 205031211878196. [Google Scholar] [CrossRef]
- Abdelnasir:, S.; Anwar, A.; Kawish, M.; Anwar, A.; Shah, M.R.; Siddiqui, R.; Khan, N.A. Metronidazole Conjugated Magnetic Nanoparticles Loaded with Amphotericin B Exhibited Potent Effects Against Pathogenic Acanthamoeba castellanii Belonging to the T4 Genotype. AMB Express 2020, 10, 127. [Google Scholar] [CrossRef]
- Costa, V.M.; de Souza, M.C.M.; Fechine, P.B.A.; Macedo, A.C.; Gonçalves, L.R.B. Nanobiocatalytic Systems Based on Lipase-Fe3O4 and Conventional Systems for Isoniazid Synthesis: A Comparative Study. Braz. J. Chem. Eng. 2016, 33, 661–673. [Google Scholar] [CrossRef]
- Hachani, R.; Lowdell, M.; Birchall, M.; Hervault, A.; Mertz, D.; Begin-Colin, S.; Thanh, N.T.K. Polyol Synthesis, Functionalisation, and Biocompatibility Studies of Superparamagnetic Iron Oxide Nanoparticles as Potential MRI Contrast Agents. Nanoscale 2016, 8, 3278–3287. [Google Scholar] [CrossRef]
- Nolasco, M.M.; Amado, A.M.; Ribeiro-Claro, P.J. Effect of hydrogen bonding in the vibrational spectra of trans-cinnamic acid. J. Raman Spectrosc. 2009, 40, 394–400. [Google Scholar] [CrossRef]
- Balakrishnan, K.; Casimeer, S.C.; Ghidan, A.Y.; Ghethan, F.Y.; Venkatachalam, K.; Singaravelu, A. Bioformulated Hesperidin-loaded PLGA Nanoparticles Counteract the Mitochondrial-Mediated Intrinsic Apoptotic Pathway in Cancer Cells. J. Inorg. Organomet. Polym. Mater. 2021, 31, 331–343. [Google Scholar] [CrossRef]
- Corciova, A.; Ciobanu, C.; Poiata, A.; Mircea, C.; Nicolescu, A.; Drobota, M.; Varganici, C.D.; Pinteala, T.; Marangoci, N. Antibacterial and Antioxidant Properties of Hesperidin: β-cyclodextrin Complexes Obtained by Different Techniques. J. Incl. Phenom. Macrocycl. Chem. 2015, 81, 71–84. [Google Scholar] [CrossRef]
- Rao, K.; Aziz, S.; Roome, T.; Razzak, A.; Sikandar, B.; Jamali, K.S.; Imran, M.; Jabri, T.; Shah, M.R. Gum Acacia Stabilized Silver Nanoparticles Based Nano-Cargo for Enhanced Anti-Arthritic Potentials of Hesperidin in Adjuvant Induced Arthritic Rats. Artif. Cells Nanomed. Biotechnol. 2018, 46, 597–607. [Google Scholar] [CrossRef] [PubMed]
- Khan, A.; Aslam, F.; Kanwal, T.; Shah, M.R.; Khalil, A.A.K.; Shah, S.W.A.; Alshammari, E.M.; El-Masry, E.A.; Batiha, G.E.S.; Baty, R.S. Enhanced Antibacterial Potential of Amoxicillin against Helicobacter pylori Mediated by Lactobionic Acid Coated Zn-MOFs. Antibiotics 2021, 10, 1071. [Google Scholar] [CrossRef]
- Akbar, N.; Kawish, M.; Jabri, T.; Khan, N.A.; Shah, M.R.; Siddiqui, R. Cinnamic Acid and Lac-tobionic Acid Based Nanoformulations as a Potential Antiamoebic Therapeutics. Available online: https://papers.ssrn.com/sol3/papers.cfm?abstract_id=4035178 (accessed on 17 May 2022).
- Sun, B.; Tian, Y.; Chen, L.; Jin, Z. Linear Dextrin as Curcumin Delivery System: Effect of Degree of Polymerization on the Functional Stability of Curcumin. Food Hydrocoll. 2018, 77, 911–920. [Google Scholar] [CrossRef]
- Habib, S.M.; Maharjan, R.; Kanwal, T.; Althagafi, I.I.; Saifullah, S.; Ullah, S.; Simjee, S.U.; Shah, M.R. Synthesis of lactobionic acid based bola-amphiphiles and its application as nano-carrier for curcumin delivery to cancer cell cultures in-vitro. Int. J. Pharm. 2020, 590, 119897. [Google Scholar] [CrossRef]
- Jabri, T.; Imran, M.; Shafiullah; Rao, K.; Ali, I.; Arfan, M.; Shah, M.R. Fabrication of Lecithin-Gum Tragacanth Muco-Adhesive Hybrid Nano-Carrier System for in-Vivo Performance of Amphotericin B. Carbohydr. Polym. 2018, 194, 89–96. [Google Scholar] [CrossRef]
- Kawish, M.; Elhissi, A.; Jabri, T.; Muhammad Iqbal, K.; Zahid, H.; Shah, M.R. Enhancement in Oral Absorption of Ceftriaxone by Highly Functionalized Magnetic Iron Oxide Nanoparticles. Pharmaceutics 2020, 12, 492. [Google Scholar] [CrossRef]
- Gutiérrez, L.; de la Cueva, L.; Moros, M.; Mazarío, E.; de Bernardo, S.; de la Fuente, J.M.; Morales, M.P.; Salas, G. Aggregation Effects on the Magnetic Properties of Iron Oxide Colloids. Nanotechnology 2019, 30, 112001. [Google Scholar] [CrossRef] [PubMed]
- Stewart, M.; Bartholomew, B.; CURrie, F.; Abbiw, D.K.; Latif, Z.; Sarker, S.D.; Nash, R.J. Pyranoisoflavones from Rinorea Welwitschii. Fitoterapia 2000, 71, 595–597. [Google Scholar] [CrossRef]
- Kong, Z.L.; Kuo, H.P.; Johnson, A.; Wu, L.C.; Chang, K.L.B. Curcumin-Loaded Mesoporous Silica Nanoparticles Markedly Enhanced Cytotoxicity in Hepatocellular Carcinoma Cells. IJMS 2019, 20, 2918. [Google Scholar] [CrossRef] [PubMed]
- Imran, M.; Shah, M.R.; Ullah, F.; Ullah, S.; Elhissi, A.M.A.; Nawaz, W.; Ahmad, F.; Sadiq, A.; Ali, I. Glycoside-Based Niosomal Nanocarrier for Enhanced in-Vivo Performance of Cefixime. Int. J. Pharm. 2016, 505, 122–132. [Google Scholar] [CrossRef] [PubMed]
- Kaasalainen, M.; Aseyev, V.; von Haartman, E.; Karaman, D.Ş.; Mäkilä, E.; Tenhu, H.; Rosenholm, J.; Salonen, J. Size, Stability, and Porosity of Mesoporous Nanoparticles Characterized with Light Scattering. Nanoscale Res. Lett. 2017, 12, 74. [Google Scholar] [CrossRef] [PubMed]
- Jamison, D.T.; Breman, J.G.; Measham, A.R.; Alleyne, G.; Claeson, M.; Evans, D.B.; Jha, P.; Mills, A.; Musgrove, P. Disease Control Priorities in Developing Countries, 2nd ed.; Jamison, D.T., Breman, J.G., Eds.; World Bank: Washington, DC, USA, 2006; ISBN 978-0-8213-6179-5. [Google Scholar]
- Gandra, S.; Klein, E.Y.; Pant, S.; Malhotra-Kumar, S.; Laxminarayan, R. Faropenem Consumption Is Increasing in India. Clin. Infect. Dis. 2016, 62, 1050–1052. [Google Scholar] [CrossRef]
- Penner, R.; Fedorak, R.; Madsen, K. Probiotics and Nutraceuticals: Non-Medicinal Treatments of Gastrointestinal Diseases. Curr. Opin. Pharmacol. 2005, 5, 596–603. [Google Scholar] [CrossRef]
- Dadgostar, P. Antimicrobial resistance: Implications and costs. Infect. Drug Resist. 2019, 12, 3903–3910. [Google Scholar] [CrossRef]
- Jasovský, D.; Littmann, J.; Zorzet, A.; Cars, O. Antimicrobial resistance—a Threat to the World’s Sustainable Development. Upsala J. Med. Sci. 2016, 121, 159–164. [Google Scholar] [CrossRef]
- Iredell, J.; Brown, J.; Tagg, K. Antibiotic Resistance in Enterobacteriaceae: Mechanisms and Clinical Implications. BMJ 2016, 352. [Google Scholar] [CrossRef]
- Baptista, P.V.; McCusker, M.P.; Carvalho, A.; Ferreira, D.A.; Mohan, N.M.; Martins, M.; Fernandes, A.R. Nano-Strategies to Fight Multidrug Resistant Bacteria—“A Battle of the Titans”. Front. Microbiol. 2018, 9, 1441. [Google Scholar] [CrossRef] [PubMed]
- Hayat, S. Nanoantibiotics Future Nanotechnologies to Combat Antibiotic Resistance. Front. Biosci. 2018, 10, 352–374. [Google Scholar] [CrossRef] [PubMed]
- Natan, M.; Banin, E. From Nano to Micro: Using Nanotechnology to Combat Microorganisms and Their Multidrug Resistance. FEMS Microbiol. Rev. 2017, 41, 302–322. [Google Scholar] [CrossRef] [PubMed]
- Singh, R.; Smitha, M.S.; Singh, S.P. The Role of Nanotechnology in Combating Multi-Drug Resistant Bacteria. J. Nanosci. Nanotechnol. 2014, 14, 4745–4756. [Google Scholar] [CrossRef]
- Beyth, N.; Houri-Haddad, Y.; Domb, A.; Khan, W.; Hazan, R. Alternative Antimicrobial Approach: Nano-Antimicrobial Materials. Evid. -Based Complementary Altern. Med. 2015, 2015, 246012. [Google Scholar] [CrossRef]
- Hemeg, H. Nanomaterials for Alternative Antibacterial Therapy. Int. J. Nanomed. 2017, 12, 8211–8225. [Google Scholar] [CrossRef]
- Pelgrift, R.Y.; Friedman, A.J. Nanotechnology as a Therapeutic Tool to Combat Microbial Resistance. Adv. Drug Deliv. Rev. 2013, 65, 1803–1815. [Google Scholar] [CrossRef]
- Slavin, Y.N.; Asnis, J.; Häfeli, U.O.; Bach, H. Metal Nanoparticles: Understanding the Mechanisms behind Antibacterial Activity. J. Nanobiotechnol. 2017, 15, 65. [Google Scholar] [CrossRef] [PubMed]
- Baginski, M.; Resat, H.; McCammon, J.A. Molecular Properties of Amphotericin B Membrane Channel: A Molecular Dynamics Simulation. Mol. Pharmacol. 1997, 52, 560–570. [Google Scholar] [CrossRef]
- Hansen, J.-E.S.; Witzke, N.M.; Nielsen, C.; Mathiesen, L.R.; Teglbjærg, L.S.; Nielsen, C.M.; Nielsen, J.O. Derivatives of Amphotericin Inhibit Infection with Human Immunodeficiency Virus in Vitro by Different Modes of Action. Antivir. Res. 1990, 14, 149–159. [Google Scholar] [CrossRef]
- Couvreur, P.; Fattal, E.; Andremont, A. Liposomes and Nanoparticles in the Treatment of Intracellu-lar Bacterial Infections. Pharm. Res. 1991, 8, 1079–1086. [Google Scholar] [CrossRef] [PubMed]
- Pinto-Alphandary, H.; Andremont, A.; Couvreur, P. Targeted delivery of antibiotics using liposomes and nanoparticles: Research and applications. Int. J. Antimicrob. Agents 2000, 13, 155–168. [Google Scholar] [CrossRef]
- Gao, P.; Nie, X.; Zou, M.; Shi, Y.; Cheng, G. Recent advances in materials for extended-release anti-biotic delivery system. J. Antibiot. 2011, 64, 625–634. [Google Scholar] [CrossRef]
- Seleem, M.N.; Munusamy, P.; Ranjan, A.; Alqublan, H.; Pickrell, G.; Sriranganathan, N. Silica-Antibiotic Hybrid Nanoparticles for Targeting Intracellular Pathogens. Antimicrob. Agents Chemother. 2009, 53, 4270–4274. [Google Scholar] [CrossRef] [PubMed]
- Balakrishnan, K.; Casimeer, S.C.; Ghidan, A.Y.; Al Antary, T.M.; Singaravelu, A. Exploration of Antioxidant, Antibacterial Activities of Green Synthesized Hesperidin Loaded PLGA Nanoparticles. Biointerface Res. Appl. Chem. 2021, 11, 14520–14528. [Google Scholar] [CrossRef]
- Somu, P.; Paul, S. Surface Conjugation of CURcumin with Self-Assembled Lysozyme Nanoparticle Enhanced Its Bioavailability and Therapeutic Efficacy in Multiple Cancer Cells. J. Mol. Liq. 2021, 338, 116623. [Google Scholar] [CrossRef]
- Shanmugam, R.; Subramaniam, R.; Kathirason, S.G.; Ali, D.; Balusamy, S.R.; Gurusamy, A.; Arunachalam, K.; Sellami, H. CURcumin-Chitosan Nanocomposite Formulation Containing Pongamia Pinnata-Mediated Silver Nanoparticles, Wound Pathogen Control, and Anti-Inflammatory Potential. BioMed Res. Int. 2021, 2021, 3091587. [Google Scholar] [CrossRef]
- Hanna, D.H.; Saad, G.R. NanoCURcumin: Preparation, Characterization and Cytotoxic Effects towards Human Laryngeal Cancer Cells. RSC Adv. 2020, 10, 20724–20737. [Google Scholar] [CrossRef]

| Bacteria | Strain |
|---|---|
| Bacillus cereus | MTCC 131621 |
| Methicillin-resistant Staphylococcus aureus | MTCC 381123 |
| Streptococcus pneumoniae | ATCC 13883 |
| Streptococcus pyogenes | ATCC 49399 |
| Salmonella enterica | ATTC 14028 |
| Escherichia coli K1 | MTCC 710859 |
| Serratia marcescens | MTTC 13880 |
| Pseudomonas aeruginosa | ATCC 10145 |
| Nanoparticles | Average Size (nm) | PDI |
|---|---|---|
| CA-MNPs | 300 ± 20.1 | 0.39 ± 0.050 |
| HES-CA-MNPs | 243.4 ± 25.3 | 0.24 ± 0.010 |
| LBA-MNPs | 153.8 ± 10.4 | 0.30 ± 0.018 |
| CUR-LBA-MNPs | 189.2 ± 5.7 | 0.18 ± 0.024 |
| AmpB-LBA-MNPs | 175.3 ± 13.5 | 0.29 ± 0.053 |
| Drugs/Formulations | P. aeruginosa | MRSA |
|---|---|---|
| MIC | MIC | |
| HES | 357.1 | 333.3 |
| HES-CA-MNPs | 136.9 | 105.25 |
| Curcumin | 416.6 | 175.5 |
| CUR-LBA-MNPs | 115.6 | 130.25 |
| AmpB | 180.8 | 141.85 |
| AmpB-LBA-MNPs | 122.5 | 25 |
Publisher’s Note: MDPI stays neutral with regard to jurisdictional claims in published maps and institutional affiliations. |
© 2022 by the authors. Licensee MDPI, Basel, Switzerland. This article is an open access article distributed under the terms and conditions of the Creative Commons Attribution (CC BY) license (https://creativecommons.org/licenses/by/4.0/).
Share and Cite
Akbar, N.; Kawish, M.; Khan, N.A.; Shah, M.R.; Alharbi, A.M.; Alfahemi, H.; Siddiqui, R. Hesperidin-, Curcumin-, and Amphotericin B- Based Nano-Formulations as Potential Antibacterials. Antibiotics 2022, 11, 696. https://doi.org/10.3390/antibiotics11050696
Akbar N, Kawish M, Khan NA, Shah MR, Alharbi AM, Alfahemi H, Siddiqui R. Hesperidin-, Curcumin-, and Amphotericin B- Based Nano-Formulations as Potential Antibacterials. Antibiotics. 2022; 11(5):696. https://doi.org/10.3390/antibiotics11050696
Chicago/Turabian StyleAkbar, Noor, Muhammad Kawish, Naveed Ahmed Khan, Muhammad Raza Shah, Ahmad M. Alharbi, Hasan Alfahemi, and Ruqaiyyah Siddiqui. 2022. "Hesperidin-, Curcumin-, and Amphotericin B- Based Nano-Formulations as Potential Antibacterials" Antibiotics 11, no. 5: 696. https://doi.org/10.3390/antibiotics11050696
APA StyleAkbar, N., Kawish, M., Khan, N. A., Shah, M. R., Alharbi, A. M., Alfahemi, H., & Siddiqui, R. (2022). Hesperidin-, Curcumin-, and Amphotericin B- Based Nano-Formulations as Potential Antibacterials. Antibiotics, 11(5), 696. https://doi.org/10.3390/antibiotics11050696

